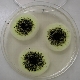
その他

業務案内Service

水質検査
飲料水/浴槽水/プール水
工場排水/公共用水域の水質検査
土壌・産廃分析
土壌汚染対策防止法に伴う分析
産業廃棄物分析/ごみ質分析
アスベスト・石綿
建材中のアスベスト
解体作業時の浮遊石綿
RCF分析
大気質測定
作業環境測定/溶接ヒューム
ばい煙測定/悪臭測定/空気環境測定
シックハウス
化学物質リスクアセスメント
騒音・振動測定
工場・建設作業の騒音振動測定
道路の騒音振動測定
大店立地法・ミニアセスに伴う調査
低周波音測定
自然環境調査
植物調査
動物調査
環境基本計画の策定
環境学習会(水辺教室の実施)-
衛生検査
食品の衛生管理
施設の衛生管理
従事者の衛生管理
HACCP導入のお手伝い
その他
異物混入などクレーム対応調査
薬剤空中散布に伴う安全確認調査
絶縁油中のPCB分析
ACCESS
〒384-2305 長野県北佐久郡
立科町芦田1835-1
⇒アクセス
☎0267-56-2189
FAX.0267-56-1843
平日8:30~17:00
⇒お問い合わせフォーム
copyright©2011 eco-skk.com all rights reserved.
